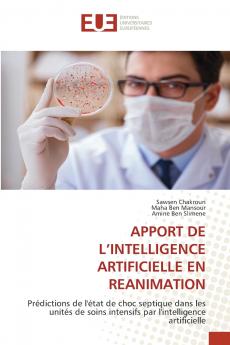
APPORT DE L'INTELLIGENCE ARTIFICIELLE EN REANIMATION

French
Paperback
₹4706
₹6001
21.58% OFF
(All inclusive*)
Delivery Options
Please enter pincode to check delivery time.
*COD & Shipping Charges may apply on certain items.
Review final details at checkout.
Looking to place a bulk order? SUBMIT DETAILS
Delivery Options
Please enter pincode to check delivery time.
*COD & Shipping Charges may apply on certain items.
Review final details at checkout.
About The Book
Description
Author(s)
La détection précoce du choc septique est cruciale pour améliorer les résultats des patients. Cette étude vise à développer un modèle d'apprentissage automatique utilisant XGBoost pour prédire le choc septique six heures à l'avance. Le modèle a été entraîné sur un ensemble de données public comprenant 40 336 patients. Il a été testé sur une partie de cet ensemble atteignant une précision de 097 et une AUC de 0874. Des prédictions ont également été faites pour 8 10 et 12 heures à l'avance donnant des précisions de 0899 0891 et 08954 et des AUC de 0867 08639 et 08530 respectivement .De plus le modèle a été testé sur un ensemble de données local de l'Hôpital Universitaire de Fattouma Bourguiba comprenant 30 patients. Pour la prédiction à 6 heures sur l'ensemble de données local le modèle a atteint une précision de 089 et une AUC de 074. Les prédictions pour 8 10 et 12 heures à l'avance ont montré des précisions de 08861 08772 et 08718 et des AUC de 073 072 et 072 respectivement. Le modèle XGBoost montre un potentiel pour la détection précoce du choc septique mais nécessite des tests et des optimisations supplémentaires pour une application clinique.
Details
ISBN 13
9786206732150
Publication Date
-03-02-2025
Pages
-52
Weight
-85 grams
Dimensions
-152x229x3.16 mm